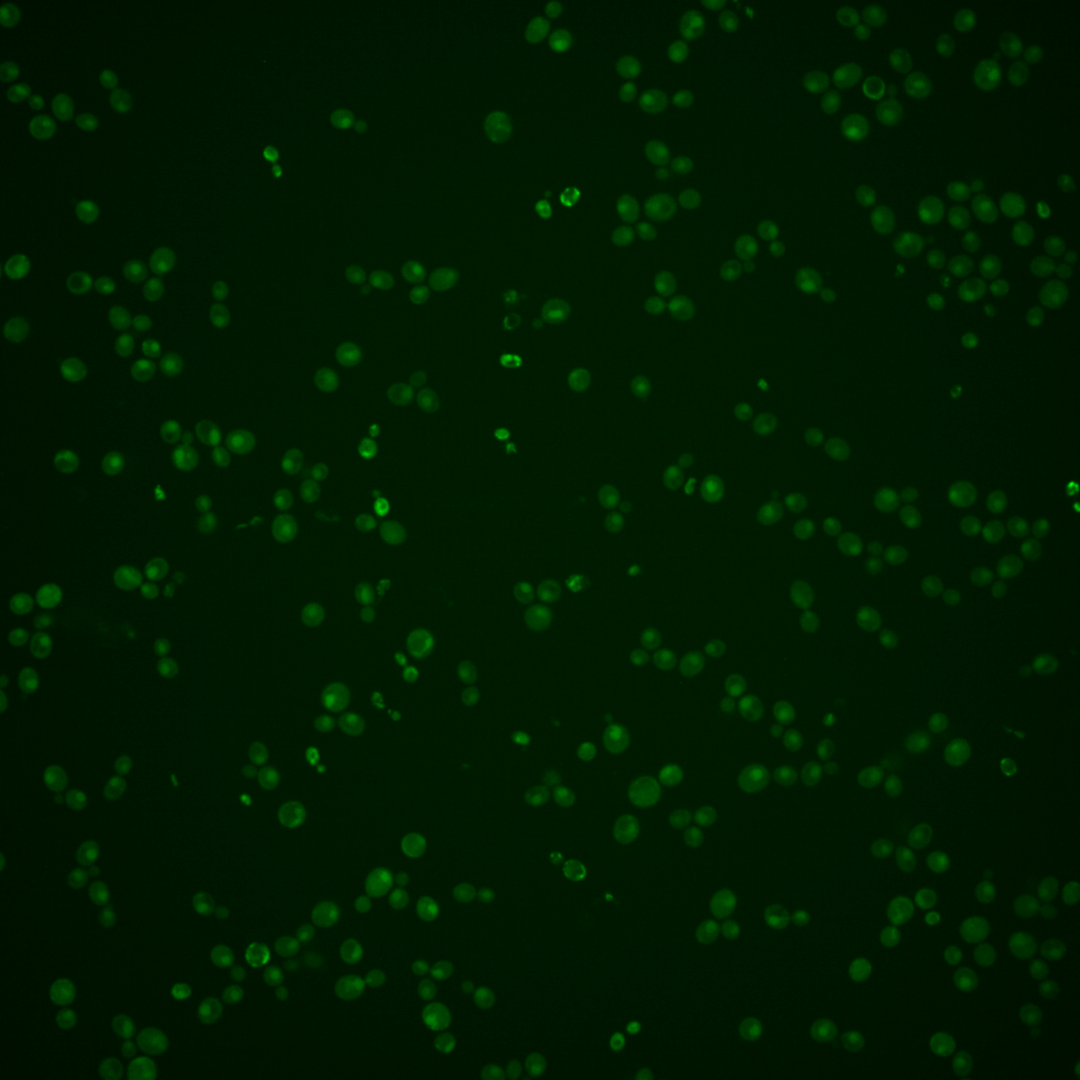
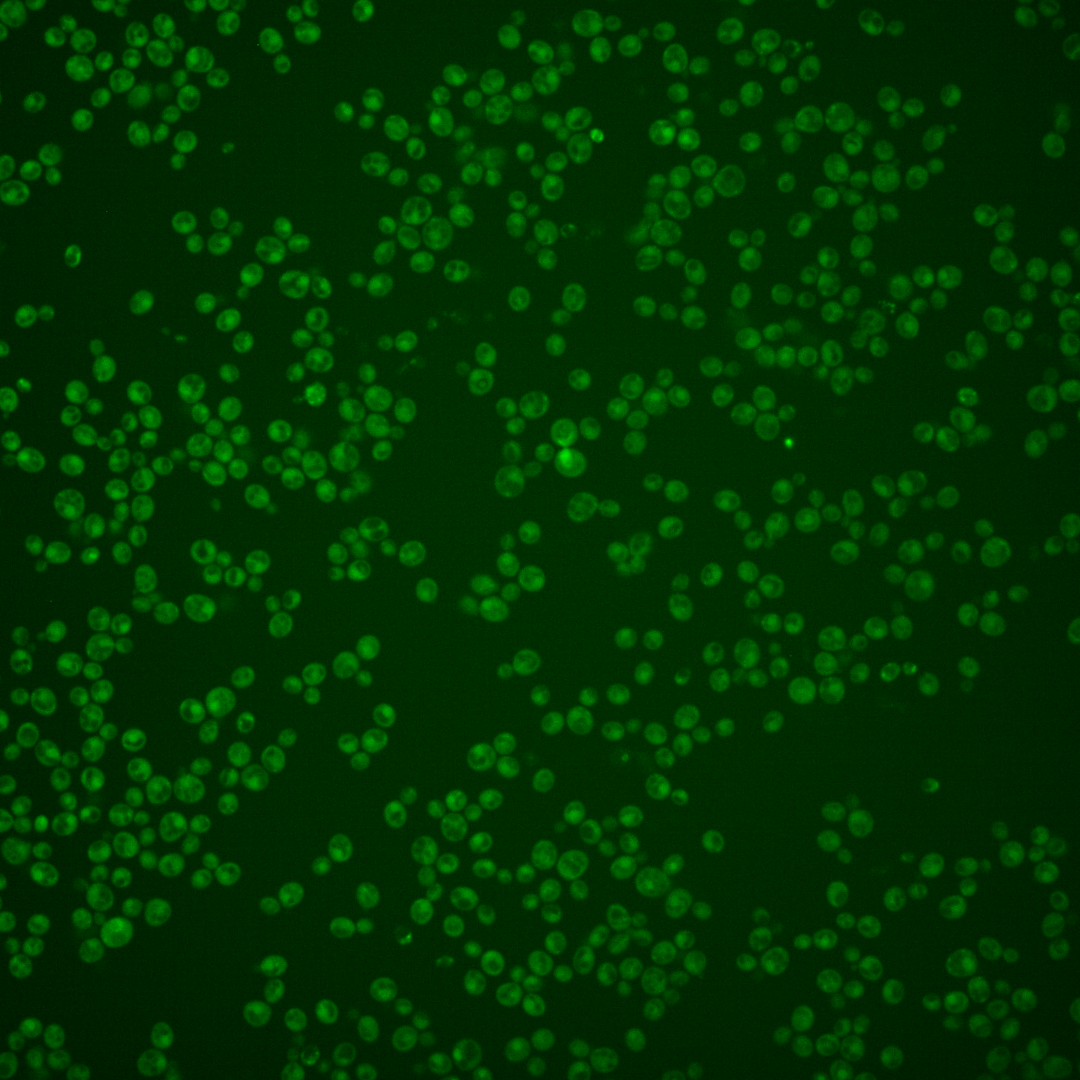
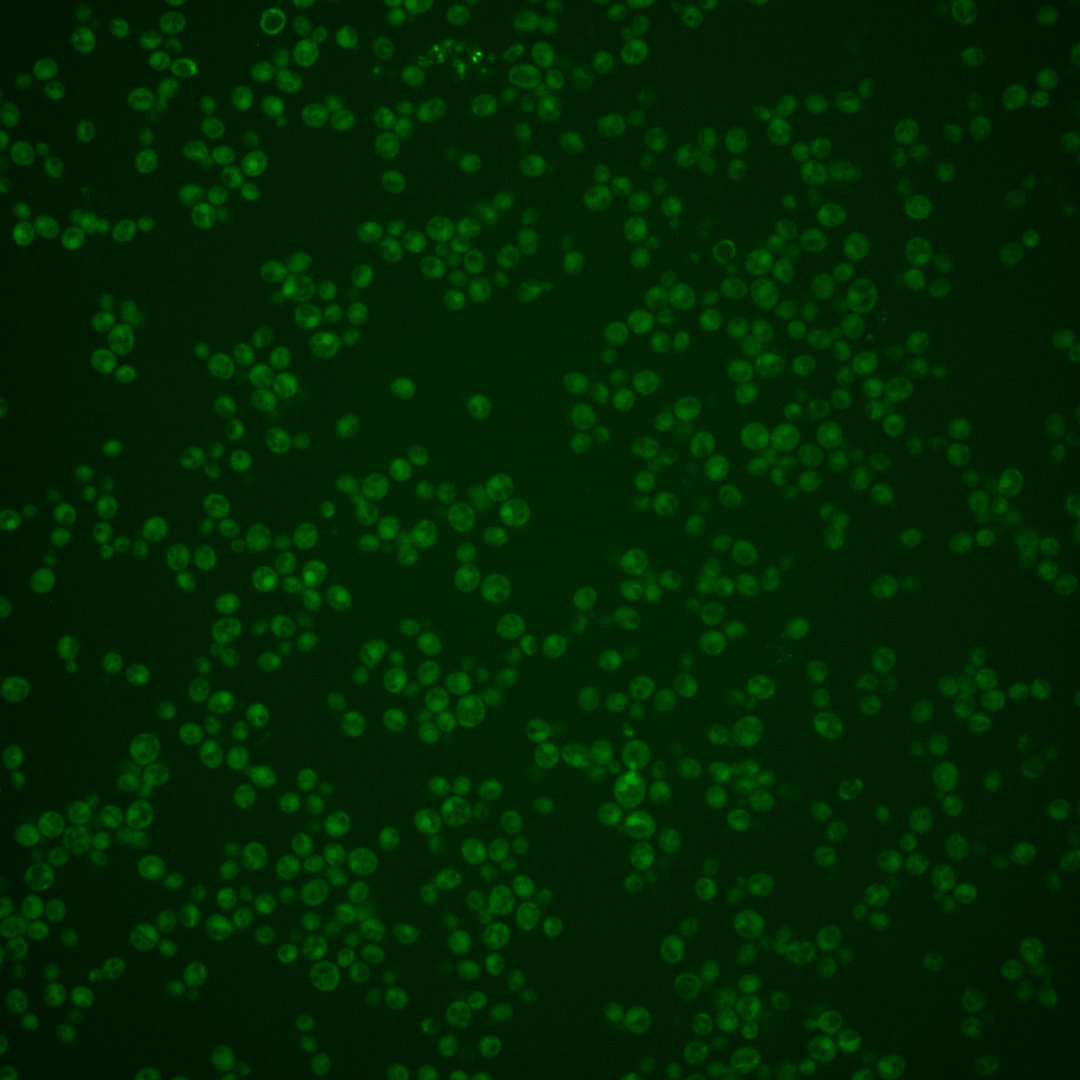
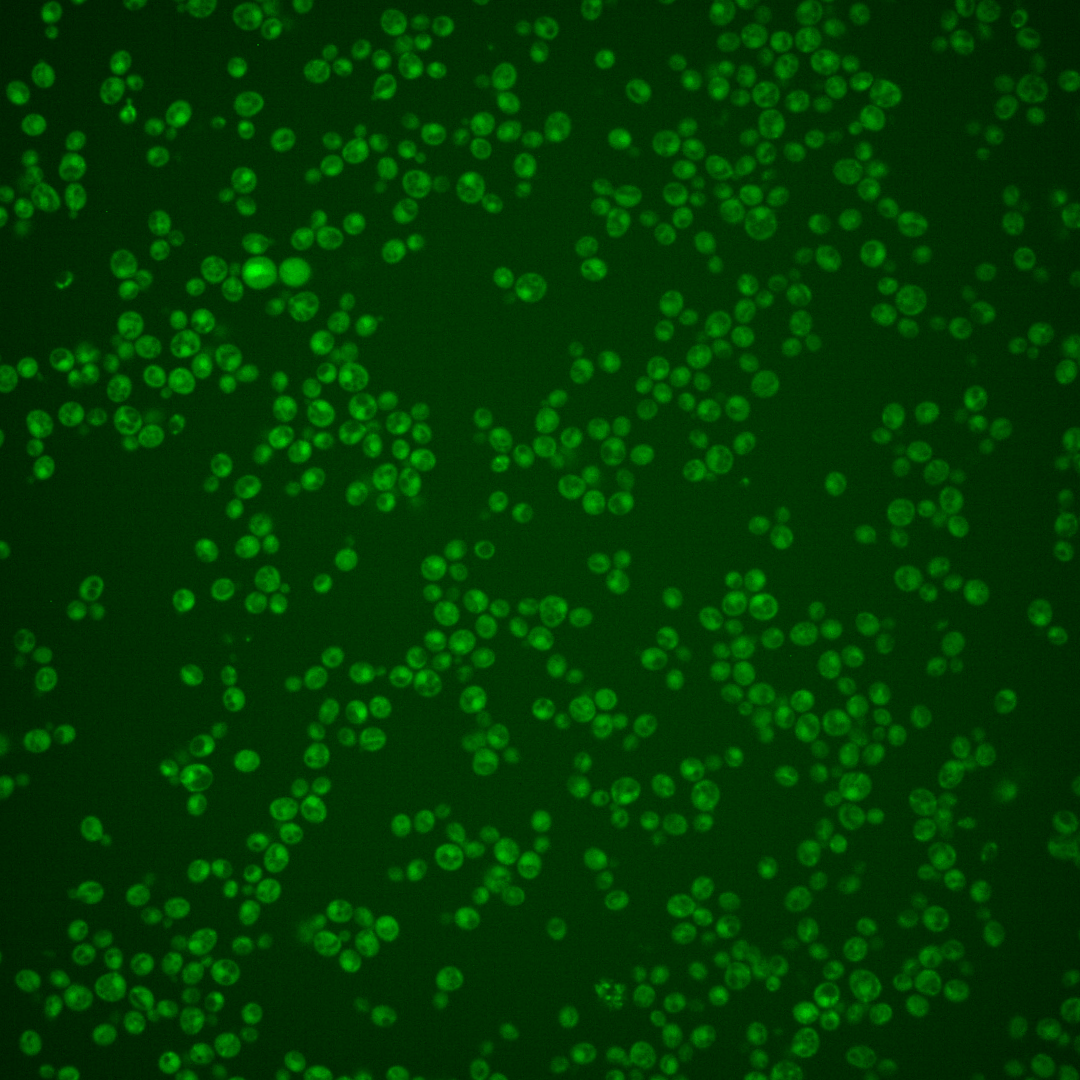

| Standard name | |
|---|---|
| Human Ortholog | |
| Description | Proton-coupled oligopeptide transporter of the plasma membrane; also transports glutathione and phytochelatin; member of the OPT family |
Micrographs




















































































Sub-cellular Localization
Yeast GFP Assignment
Protein Abundance
Localization Change
External localization resources
| ensLOC | DeepLoc | |||||||||||||||||||||||
|---|---|---|---|---|---|---|---|---|---|---|---|---|---|---|---|---|---|---|---|---|---|---|---|---|
| Localization | WT1 | WT2 | WT3 | RAP60 | RAP140 | RAP220 | RAP300 | RAP380 | RAP460 | RAP540 | RAP620 | RAP700 | HU80 | HU120 | HU160 | rpd3Δ_1 | rpd3Δ_2 | rpd3Δ_3 | WT1 | WT2 | WT3 | AF100 | AF140 | AF180 |
| Cortical Patches | 0 | 1 | 0 | 0 | 0 | 0 | 0 | 0 | – | 0 | 0 | 0 | 0 | 0 | 0 | – | – | – | 4 | 3 | 7 | 2 | 2 | 3 |
| Bud | 0 | 2 | 1 | 1 | 1 | 3 | 11 | 6 | – | 10 | 10 | 13 | 0 | 0 | 0 | – | – | – | 8 | 5 | 7 | 0 | 5 | 8 |
| Bud Neck | 2 | 1 | 4 | 2 | 4 | 0 | 4 | 9 | – | 2 | 4 | 2 | 0 | 0 | 0 | – | – | – | 2 | 1 | 2 | 1 | 2 | 5 |
| Bud Site | 0 | 0 | 0 | 0 | 0 | 2 | 2 | 0 | – | 3 | 1 | 1 | 0 | 0 | 0 | – | – | – | – | – | – | – | – | – |
| Cell Periphery | 2 | 1 | 2 | 2 | 0 | 1 | 0 | 1 | – | 1 | 1 | 0 | 2 | 0 | 0 | – | – | – | 1 | 1 | 2 | 3 | 4 | 2 |
| Cytoplasm | 421 | 384 | 372 | 255 | 346 | 366 | 453 | 361 | – | 356 | 280 | 264 | 125 | 272 | 250 | – | – | – | 346 | 332 | 264 | 215 | 258 | 302 |
| Endoplasmic Reticulum | 1 | 2 | 1 | 1 | 0 | 0 | 0 | 0 | – | 0 | 0 | 3 | 0 | 0 | 1 | – | – | – | 0 | 0 | 4 | 2 | 1 | 1 |
| Endosome | 2 | 0 | 1 | 0 | 2 | 1 | 0 | 2 | – | 1 | 0 | 0 | 0 | 1 | 0 | – | – | – | 5 | 3 | 4 | 1 | 1 | 2 |
| Golgi | 2 | 0 | 1 | 0 | 0 | 0 | 0 | 0 | – | 0 | 0 | 0 | 0 | 0 | 0 | – | – | – | 3 | 0 | 2 | 3 | 0 | 0 |
| Mitochondria | 7 | 21 | 12 | 21 | 38 | 138 | 232 | 174 | – | 277 | 243 | 325 | 0 | 0 | 0 | – | – | – | 33 | 28 | 55 | 28 | 28 | 23 |
| Nucleus | 0 | 0 | 0 | 1 | 0 | 2 | 0 | 3 | – | 1 | 2 | 1 | 1 | 1 | 1 | – | – | – | 0 | 0 | 0 | 0 | 0 | 0 |
| Nuclear Periphery | 1 | 0 | 0 | 0 | 0 | 0 | 0 | 0 | – | 3 | 0 | 0 | 0 | 0 | 0 | – | – | – | 0 | 0 | 0 | 0 | 0 | 0 |
| Nucleolus | 0 | 1 | 0 | 0 | 1 | 1 | 1 | 2 | – | 0 | 3 | 0 | 0 | 0 | 0 | – | – | – | 0 | 0 | 0 | 0 | 0 | 0 |
| Peroxisomes | 0 | 0 | 0 | 0 | 1 | 1 | 0 | 0 | – | 0 | 0 | 2 | 0 | 0 | 0 | – | – | – | 1 | 0 | 1 | 0 | 0 | 0 |
| SpindlePole | 1 | 1 | 2 | 1 | 1 | 7 | 11 | 7 | – | 16 | 13 | 16 | 1 | 0 | 0 | – | – | – | 8 | 2 | 7 | 3 | 3 | 6 |
| Vac/Vac Membrane | 2 | 1 | 2 | 0 | 3 | 3 | 7 | 3 | – | 0 | 1 | 2 | 0 | 0 | 0 | – | – | – | 4 | 4 | 7 | 6 | 4 | 7 |
| Unique Cell Count | 434 | 397 | 385 | 263 | 364 | 436 | 581 | 477 | 526 | 427 | 494 | 127 | 274 | 251 | 430 | 394 | 381 | 280 | 323 | 374 | ||||
| Labelled Cell Count | 441 | 415 | 398 | 284 | 397 | 525 | 721 | 568 | 670 | 558 | 629 | 129 | 274 | 252 | 430 | 394 | 381 | 280 | 323 | 374 | ||||
Yeast GFP Assignment
Protein Abundance
| Screen | WT1 | WT2 | WT3 | RAP60 | RAP140 | RAP220 | RAP300 | RAP380 | RAP460 | RAP540 | RAP620 | RAP700 | HU80 | HU120 | HU160 | rpd3Δ_1 | rpd3Δ_2 | rpd3Δ_3 | AF100 | AF140 | AF180 |
|---|---|---|---|---|---|---|---|---|---|---|---|---|---|---|---|---|---|---|---|---|---|
| Mean Cell GFP Intensity (1e-4) | 3.9 | 3.4 | 3.4 | 3.2 | 3.1 | 2.6 | 2.4 | 3.0 | – | 2.2 | 2.2 | 2.4 | 4.4 | 5.0 | 4.9 | 3.9 | 4.0 | 4.6 | 4.9 | 4.9 | 5.1 |
| Std Deviation (1e-4) | 0.8 | 0.5 | 1.6 | 1.3 | 1.1 | 1.0 | 0.9 | 1.9 | – | 1.0 | 0.6 | 0.9 | 0.8 | 1.5 | 1.0 | 1.2 | 0.9 | 1.3 | 1.5 | 1.3 | 1.4 |
| Intensity Change (Log2) | – | – | – | -0.12 | -0.12 | -0.42 | -0.52 | -0.19 | – | -0.62 | -0.64 | -0.53 | 0.37 | 0.55 | 0.51 | 0.18 | 0.21 | 0.43 | 0.5 | 0.52 | 0.57 |
Localization Change
| Localization | RAP60 | RAP140 | RAP220 | RAP300 | RAP380 | RAP460 | RAP540 | RAP620 | RAP700 | HU80 | HU120 | HU160 | rpd3Δ_1 | rpd3Δ_2 | rpd3Δ_3 |
|---|---|---|---|---|---|---|---|---|---|---|---|---|---|---|---|
| Actin | – | – | – | – | – | – | – | – | – | – | – | – | – | – | – |
| Bud | – | – | – | – | – | – | – | – | – | – | – | – | – | – | – |
| Bud Neck | – | – | – | – | – | – | – | – | – | – | – | – | – | – | – |
| Bud Site | – | – | – | – | – | – | – | – | – | – | – | – | – | – | – |
| Cell Periphery | – | – | – | – | – | – | – | – | – | – | – | – | – | – | – |
| Cyto | – | – | – | – | – | – | – | – | – | – | – | – | – | – | – |
| Endoplasmic Reticulum | – | – | – | – | – | – | – | – | – | – | – | – | – | – | – |
| Endosome | – | – | – | – | – | – | – | – | – | – | – | – | – | – | – |
| Golgi | – | – | – | – | – | – | – | – | – | – | – | – | – | – | – |
| Mitochondria | – | – | – | – | – | – | – | – | – | – | – | – | – | – | – |
| Nuclear Periphery | – | – | – | – | – | – | – | – | – | – | – | – | – | – | – |
| Nuc | – | – | – | – | – | – | – | – | – | – | – | – | – | – | – |
| Nucleolus | – | – | – | – | – | – | – | – | – | – | – | – | – | – | – |
| Peroxisomes | – | – | – | – | – | – | – | – | – | – | – | – | – | – | – |
| SpindlePole | – | – | – | – | – | – | – | – | – | – | – | – | – | – | – |
| Vac | – | – | – | – | – | – | – | – | – | – | – | – | – | – | – |
| Cortical Patches | – | – | – | – | – | – | – | – | – | – | – | – | – | – | – |
| Cytoplasm | – | – | – | – | – | – | – | – | – | – | – | – | – | – | – |
| Nucleus | – | – | – | – | – | – | – | – | – | – | – | – | – | – | – |
| Vacuole | – | – | – | – | – | – | – | – | – | – | – | – | – | – | – |
External localization resources
Images






























Protein Concentration and Protein Localization Data
| R1 | R2 | R3 | ||||||||||||||||
|---|---|---|---|---|---|---|---|---|---|---|---|---|---|---|---|---|---|---|
| G1 Pre-START | G1 Post-START | S/G2 | Metaphase | Anaphase | Telophase | G1 Pre-START | G1 Post-START | S/G2 | Metaphase | Anaphase | Telophase | G1 Pre-START | G1 Post-START | S/G2 | Metaphase | Anaphase | Telophase | |
| Concentration | – | – | – | – | – | – | – | – | – | – | – | – | – | – | – | – | – | – |
| Actin | 0.0793 | 0.0013 | 0.0325 | 0.0037 | 0.0065 | 0.0074 | 0.0271 | 0.0001 | 0.0252 | 0.0043 | 0.0017 | 0.0006 | – | – | – | – | – | – |
| Bud | 0.0032 | 0.0025 | 0.0064 | 0.0009 | 0.0003 | 0.0079 | 0.0011 | 0.0002 | 0.0029 | 0.0007 | 0.001 | 0.0001 | – | – | – | – | – | – |
| Bud Neck | 0.0075 | 0.0001 | 0.0039 | 0.0003 | 0.0002 | 0.0071 | 0.0039 | 0.0001 | 0.0006 | 0.0005 | 0 | 0.0001 | – | – | – | – | – | – |
| Bud Periphery | 0.0076 | 0.0054 | 0.0086 | 0.0055 | 0.0011 | 0.0018 | 0.0038 | 0.0003 | 0.0033 | 0.0045 | 0.0028 | 0.0001 | – | – | – | – | – | – |
| Bud Site | 0.0088 | 0.004 | 0.0073 | 0.0007 | 0.0003 | 0.0009 | 0.0055 | 0.0014 | 0.0075 | 0.0014 | 0.0001 | 0 | – | – | – | – | – | – |
| Cell Periphery | 0.001 | 0.0003 | 0.0018 | 0.0004 | 0.0001 | 0.0001 | 0.0014 | 0.0001 | 0.0002 | 0.0005 | 0.0001 | 0 | – | – | – | – | – | – |
| Cytoplasm | 0.0188 | 0.0247 | 0.0299 | 0.0172 | 0.0369 | 0.0289 | 0.0224 | 0.024 | 0.0307 | 0.0696 | 0.0367 | 0.0184 | – | – | – | – | – | – |
| Cytoplasmic Foci | 0.0208 | 0.0048 | 0.006 | 0.0025 | 0.0154 | 0.005 | 0.0449 | 0.0016 | 0.004 | 0.0023 | 0.0067 | 0.0024 | – | – | – | – | – | – |
| Eisosomes | 0.0009 | 0.0003 | 0.0004 | 0.0004 | 0.0001 | 0.0001 | 0.0007 | 0.0002 | 0.0003 | 0.0008 | 0.0002 | 0.0001 | – | – | – | – | – | – |
| Endoplasmic Reticulum | 0.0041 | 0.001 | 0.0015 | 0.0028 | 0.002 | 0.0004 | 0.0171 | 0.0003 | 0.001 | 0.0006 | 0.0005 | 0.0005 | – | – | – | – | – | – |
| Endosome | 0.0192 | 0.0017 | 0.0044 | 0.0039 | 0.0216 | 0.0018 | 0.0363 | 0.0001 | 0.0024 | 0.0004 | 0.0011 | 0.0053 | – | – | – | – | – | – |
| Golgi | 0.0163 | 0.0003 | 0.0032 | 0.0026 | 0.0226 | 0.0015 | 0.0072 | 0 | 0.0024 | 0.0001 | 0.0002 | 0.0009 | – | – | – | – | – | – |
| Lipid Particles | 0.0195 | 0.0005 | 0.0024 | 0.0054 | 0.0046 | 0.0022 | 0.0224 | 0.0001 | 0.0029 | 0.0002 | 0.0042 | 0.0002 | – | – | – | – | – | – |
| Mitochondria | 0.0144 | 0.0011 | 0.0071 | 0.0191 | 0.0269 | 0.0004 | 0.004 | 0.0002 | 0.0093 | 0.0004 | 0.0004 | 0.0003 | – | – | – | – | – | – |
| None | 0.7334 | 0.9414 | 0.8684 | 0.9289 | 0.8566 | 0.93 | 0.7406 | 0.9702 | 0.8927 | 0.9118 | 0.9394 | 0.9698 | – | – | – | – | – | – |
| Nuclear Periphery | 0.0143 | 0.0009 | 0.0017 | 0.0007 | 0.0011 | 0.0004 | 0.0238 | 0.0001 | 0.0013 | 0.0003 | 0.0013 | 0.0003 | – | – | – | – | – | – |
| Nucleolus | 0.0021 | 0.0009 | 0.0022 | 0.0004 | 0.0001 | 0.0008 | 0.0017 | 0.0002 | 0.0003 | 0.0002 | 0.0002 | 0 | – | – | – | – | – | – |
| Nucleus | 0.0114 | 0.0032 | 0.0038 | 0.0004 | 0.0002 | 0.0014 | 0.0034 | 0.0003 | 0.0037 | 0.0003 | 0.0002 | 0.0001 | – | – | – | – | – | – |
| Peroxisomes | 0.0062 | 0.0002 | 0.003 | 0.0019 | 0.0014 | 0.0007 | 0.0158 | 0.0001 | 0.0072 | 0.0005 | 0.0007 | 0.0001 | – | – | – | – | – | – |
| Punctate Nuclear | 0.0068 | 0.004 | 0.0027 | 0.0003 | 0.0005 | 0.0007 | 0.0096 | 0.0003 | 0.0005 | 0.0003 | 0.0019 | 0.0002 | – | – | – | – | – | – |
| Vacuole | 0.0032 | 0.0011 | 0.0024 | 0.0014 | 0.001 | 0.0006 | 0.0042 | 0.0002 | 0.0011 | 0.0003 | 0.0002 | 0.0003 | – | – | – | – | – | – |
| Vacuole Periphery | 0.0014 | 0.0002 | 0.0005 | 0.0006 | 0.0005 | 0.0001 | 0.0031 | 0 | 0.0004 | 0.0001 | 0.0002 | 0.0002 | – | – | – | – | – | – |
Sequencing Data
| R1 | R2 | |||||||||
|---|---|---|---|---|---|---|---|---|---|---|
| G1 Post-START | S/G2 | Metaphase | Anaphase | Telophase | G1 Post-START | S/G2 | Metaphase | Anaphase | Telophase | |
| Gene Expression | 51.7221 | 50.1408 | 71.6685 | 84.0963 | 48.5812 | 32.1648 | 53.2945 | 59.0388 | 61.0499 | 64.3821 |
| Translational Efficiency | 0.9027 | 0.9706 | 1.0487 | 0.9829 | 0.9945 | 1.0549 | 0.7817 | 0.8198 | 0.9065 | 0.7503 |
Hit Data
| Dataset | Hit |
|---|---|
| Protein Concentration | – |
| Protein Localization | ✘ |
| Gene Expression | ✔ |
| Translational Efficiency | ✔ |
Endocytosis
| Temp | Actin Patch (Sac6-tdTomato) | Cortical Patch (Sla1-GFP) | Late Endosome (Snf7-GFP) | Vacuole (Vph1-GFP) |
|---|---|---|---|---|
| 37℃ | ||||
| RT |
Cell Cycle Omics
CYCLoPs (Opt1-GFP)
| Gene / Allele | Actin Patch (Sac6-tdTomato) | Cortical Patch (Sla1-GFP) | Late Endosome (Snf7-GFP) | Vacuole (Sac6-tdTomato) |
|---|
| Gene | Images |
|---|
| Gene | Images |
|---|
Images are not yet available
Images are not yet available